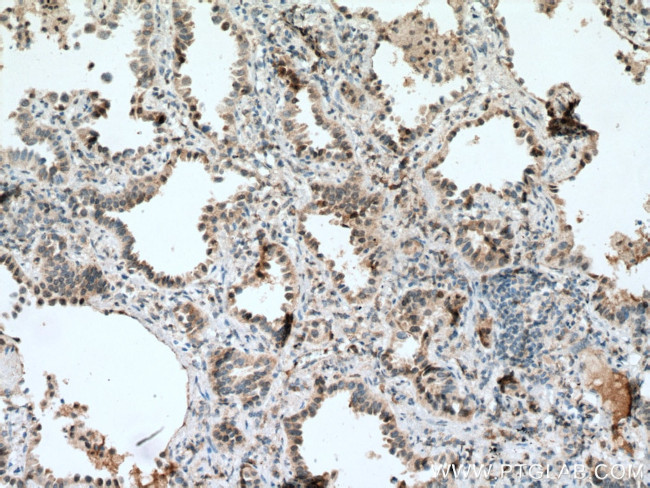
BACH1 Antibody in Immunohistochemistry (Paraffin) (IHC (P))

Search
Proteintech
BACH1 Monoclonal Antibody (2D12A4)
{{$productOrderCtrl.translations['antibody.pdp.commerceCard.promotion.promotions']}}
{{$productOrderCtrl.translations['antibody.pdp.commerceCard.promotion.viewpromo']}}
{{$productOrderCtrl.translations['antibody.pdp.commerceCard.promotion.promocode']}}: {{promo.promoCode}} {{promo.promoTitle}} {{promo.promoDescription}}. {{$productOrderCtrl.translations['antibody.pdp.commerceCard.promotion.learnmore']}}
产品信息
66762-1-IG
种属反应
宿主/亚型
分类
类型
克隆号
抗原
偶联物
形式
浓度
纯化类型
保存液
内含物
保存条件
运输条件
产品详细信息
Immunogen sequence: SSVEREVAE HLAKGFWSDI CSTDTPCQMQ LSPAVAKDGS EQISQKRSEC PWLGIRISES PEPGQRTFTT LSSVNCPFIS TLSTEGCSSN LEIGNDDYVS EPQQEPCPYA CVISLGDDSE TDTEGDSESC SAREQECEVK LPFNAQRIIS LSRNDFQSLL KMHKLTPEQL DCIHDIRRRS KNRIAAQRCR KRKLDCIQNL ESEIEKLQSE KESLLKERDH ILSTLGETKQ NLTGLCQKVC KEAALSQEQI QILAKYSAAD CPLSFLISEK DKSTPDGELA LPSIFSLSDR PPAVLPPCAR GNSEPGYARG QESQQMSTAT SEQAGPAEQC RQSGGISDFC QQMTDKCTTD E (387-736 aa encoded by BC063307)
靶标信息
BACH1.3 is a transcription factor that belongs to the cap'n'collar type of basic region leucine zipper factor family (CNC-bZip). The encoded protein contains broad complex, tramtrack, bric-a-brac/poxvirus and zinc finger (BTB/POZ) domains, which is atypical of CNC-bZip family members. These BTB/POZ domains facilitate protein-protein interactions and formation of homo and/or hetero oligomers. When this encoded protein forms a heterodimer with MafK, it functions as a repressor of Maf recognition element (MARE) and transcription is repressed. Multiple alternatively spliced transcript variants have been identified for this gene. Some exons of this gene overlap with some exons from the C21orf41 gene, which is transcribed in an opposite orientation to this gene, but which does not seem to encode a protein.
仅用于科研。不用于诊断过程。未经明确授权不得转售。
生物信息学
蛋白别名: basic region leucine zipper transcriptional regulator BACH1; BTB and CNC homolog 1; BTB and CNC homology 1 transcription factor; BTB and CNC homology 1, basic leucine zipper transcription factor 1; HA2303; Transcription regulator protein BACH1
基因别名: 6230421P05Rik; AI323795; BACH-1; BACH1; BTBD24
UniProt ID: (Human) O14867, (Mouse) P97302
Entrez Gene ID: (Pig) 100523514, (Human) 571, (Rabbit) 100353797, (Mouse) 12013, (Rat) 304127